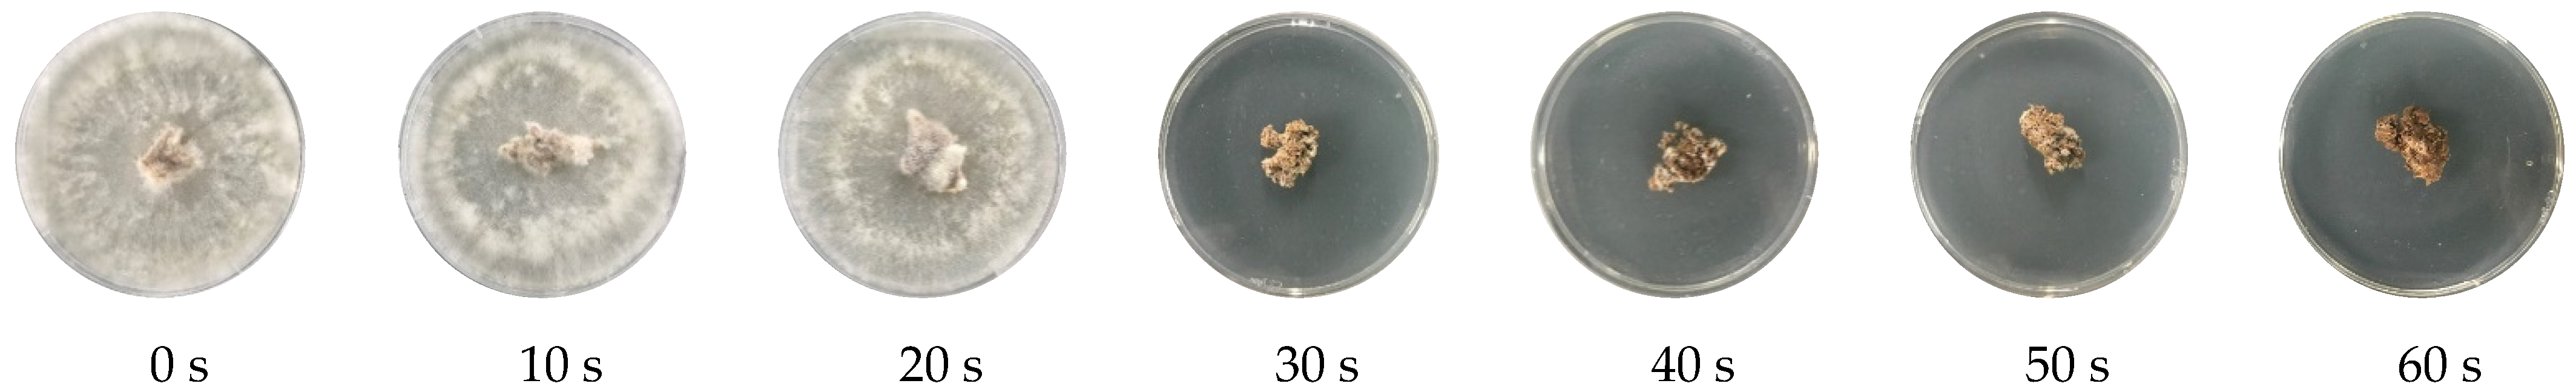
Foods 11 01766 g003

Influence of Radio Frequency Heating on the Pasteurization and Drying of Solid-State Fermented Wolfiporia cocos Products
Abstract
:1. Introduction
2. Materials and Methods
2.1. Materials
2.2. Equipment
2.3. Sample Preparation
2.3.1. Maintenance and Pre-Activation of W. cocos
2.3.2. Solid-State Fermentation of W. cocos
2.4. Pasteurizing and Drying Solid-State Fermented W. cocos Products
2.4.1. RF Output Power Measurement
2.4.2. RF Pasteurization
2.4.3. Heating and Drying Curves of Solid-State Fermented W. cocos Products during Hot-Air-Assisted RF Drying
2.4.4. Autoclaving and Hot-Air-Drying of the Solid-State Fermented W. Cocos Products
2.5. Extraction of Solid-State Fermented W. cocos Products
2.6. Analytical Methods
2.6.1. Moisture Content
2.6.2. Color Measurement
2.6.3. Mycelium Determination of Solid-State Fermented W. Cocos Products
2.6.4. Crude Polysaccharide Analysis
2.6.5. Crude Triterpenoid Analysis
2.6.6. Total Phenol Analysis
2.6.7. Total Flavonoid Analysis
2.6.8. DPPH Radical Scavenging Activity
2.6.9. Ferric-Reducing Antioxidant Power (FRAP) Assay
2.6.10. Reducing Power
2.7. Statistical Analysis
3. Results and Discussion
3.1. RF Pasteurization Conditions of Solid-State Fermented W. cocos Products
3.2. RF Drying Conditions of Solid-State Fermented W. cocos Products
3.3. Active Component and Antioxidant Activity of the Solid-State Fermented W. cocos Mycelia Products
4. Conclusions
Author Contributions
Funding
Data Availability Statement
Acknowledgments
Conflicts of Interest
References
- Chen, B.-H.; Yang, Y.-C.; Chen, S.-D. Study on hypoglycemic activities of Poria cocos solid-state fermented products. Taiwan J. Agric. Chem. Food Sci. 2017, 53, 34–42. [Google Scholar]
- Chu, B.F.; Lin, H.C.; Huang, X.W.; Huang, H.Y.; Wu, C.P.; Kao, M.C. An ethanol extract of Poria cocos inhibits the proliferation of non-small cell lung cancer A549 cells via the mitochondria-mediated caspase activation pathway. J. Funct. Foods 2016, 23, 614–627. [Google Scholar] [CrossRef]
- Zhang, J.H.; Tatsumi, E.; Ding, C.H.; Li, L.T. Angiotensin I-converting enzyme inhibitory peptides in douchi, a Chinese traditional fermented soybean product. Food Chem. 2006, 98, 551–557. [Google Scholar] [CrossRef]
- Li, T.H.; Hou, C.C.; Chang, C.L.T.; Yang, W.C. Anti-hyperglycemic properties of crude extract and triterpenes from Poria cocos. Evid. Based Complementary Altern. Med. 2011, 2011, 128402. [Google Scholar] [CrossRef] [Green Version]
- Wang, Y.; Xu, W.; Chen, Y. Surface modification on polyurethanes by using bioactive carboxymethylated fungal glucan from Poria cocos. Colloids Surf. B 2010, 81, 629–633. [Google Scholar] [CrossRef]
- Chen, Y.-H.; Yen, Y.-F.; Chen, S.-D. Study of radio frequency drying on soybean residue. Taiwan. J. Agric. Chem. Food Sci. 2017, 55, 128–291. [Google Scholar]
- Chen, Y.-H.; Yen, Y.-F.; Chen, S.-D. Effects of radio frequency heating on the stability and antioxidant properties of rice bran. Foods 2021, 10, 810. [Google Scholar] [CrossRef]
- Marra, F.; Zhang, L.; Lyng, J.G. Radio frequency treatment of foods: Review of recent advances. J. Food Eng. 2009, 91, 497–508. [Google Scholar] [CrossRef]
- Zhou, X.; Wang, S. Recent developments in radio frequency drying of food and agricultural products: A review. Dry. Technol. 2018, 37, 271–286. [Google Scholar] [CrossRef]
- Dag, D.; Singh, R.K.; Kong, F. Developments in radio frequency pasteurization of food powders. Food Rev. Int. 2020, 38, 1197–1214. [Google Scholar] [CrossRef]
- Wang, Y.; Li, Y.; Wang, S.; Zhang, L.; Gao, M.; Tang, J. Review of dielectric drying of foods and agricultural products. Int. J. Agric. Biol. Eng. 2011, 4, 1–19. [Google Scholar]
- Ozturk, S.; Kong, F.; Trabelsi, S.; Singh, R.K. Dielectric properties of dried vegetable powders and their temperature profile during radio frequency heating. J. Food Eng. 2016, 169, 91–100. [Google Scholar] [CrossRef]
- Ha, J.W.; Kim, S.Y.; Ryu, S.R.; Kang, D.H. Inactivation of Salmonella enterica serovar Typhimurium and Escherichia coli O157: H7 in peanut butter cracker sandwiches by radio-frequency heating. Food Microbiol. 2013, 34, 145–150. [Google Scholar] [CrossRef] [PubMed]
- Kim, S.Y.; Sagong, H.G.; Choi, S.H.; Ryu, S.; Kang, D.H. Radio-frequency heating to inactivate Salmonella Typhimurium and Escherichia coli O157: H7 on black and red pepper spice. Int. J. Food Microbiol. 2012, 153, 171–175. [Google Scholar] [CrossRef]
- Liu, Y.; Tang, J.; Mao, Z.; Mah, J.H.; Jiao, S.; Wang, S. Quality and mold control of enriched white bread by combined radio frequency and hot air treatment. J. Food Eng. 2011, 104, 492–498. [Google Scholar] [CrossRef]
- Wei, X.; Lau, S.K.; Reddy, B.S.; Subbiah, J. A microbial challenge study for validating continuous radio-frequency assisted thermal processing pasteurization of egg white powder. Food Microbiol. 2020, 85, 103306. [Google Scholar] [CrossRef]
- Lin, Y.; Subbiah, J.; Chen, L.; Verma, T.; Liu, Y. Validation of radio frequency assisted traditional thermal processing for pasteurization of powdered infant formula milk. Food Control 2020, 109, 106897. [Google Scholar] [CrossRef]
- Jiang, H.; Gu, Y.; Gou, M.; Xia, T.; Wang, S. Radio frequency pasteurization and disinfestation techniques applied on low-moisture foods. Crit. Rev. Food Sci. Nutr. 2020, 60, 1417–1430. [Google Scholar] [CrossRef]
- Zhang, L.; Ma, H.; Wang, S. Pasteurization mechanism of S. aureus ATCC 25923 in walnut shells using radio frequency energy at lab level. LWT-Food Sci. Technol. 2021, 143, 111129. [Google Scholar] [CrossRef]
- Wang, Y.; Zhang, L.; Johnson, J.; Gao, M.; Tang, J.; Powers, J.R.; Wang, S. Developing hot air-assisted radio frequency drying for in-shell macadamia nuts. Food Technol. Biotechnol. 2014, 7, 278–288. [Google Scholar] [CrossRef]
- Zhang, B.; Zheng, A.; Zhou, L.; Huang, Z.; Wang, S. Developing hot air-assisted radio frequency drying protocols for in-shell walnuts. Emir. J. Food Agric. 2016, 28, 459–467. [Google Scholar] [CrossRef] [Green Version]
- Wang, C.; Kou, X.; Zhou, X.; Li, R.; Wang, S. Effects of layer arrangement on heating uniformity and product quality after hot air assisted radio frequency drying of carrot. Innov. Food Sci. Emerg. Technol. 2021, 69, 102667. [Google Scholar] [CrossRef]
- Zhou, X.; Xu, R.; Zhang, B.; Pei, S.; Liu, Q.; Ramaswamy, H.S.; Wang, S. Radio frequency-vacuum drying of kiwifruits: Kinetics, uniformity, and product quality. Food Bioprocess Technol. 2018, 11, 2094–2109. [Google Scholar] [CrossRef] [Green Version]
- Ran, X.L.; Zhang, M.; Wang, Y.; Liu, Y. Vacuum radio frequency drying: A novel method to improve the main qualities of chicken powders. J. Food Sci. Technol. 2019, 56, 4482–4491. [Google Scholar] [CrossRef]
- Chen, B.-H.; Chen, S.-D. Microwave extraction of polysaccharides and triterpenoids from solid-state fermented products of Poria cocos. Taiwan. J. Agric. Chem. Food Sci. 2013, 51, 188–194. [Google Scholar]
- Chang, C.Y.; Lue, M.Y.; Pan, T.M. Determination of adenosine, cordycepin and ergosterol contents in cultivated Antrodia camphorata by HPLC method. J. Food Drug Anal. 2005, 13, 338–342. [Google Scholar] [CrossRef]
- DuBois, M.; Gilles, K.A.; Hamilton, J.K.; Rebers, P.T.; Smith, F. Colorimetric method for determination of sugars and related substances. Anal. Chem. 1956, 28, 350–356. [Google Scholar] [CrossRef]
- Sun, Z.; Liu, H.; Huang, Y.; Ju, J. Determination of total triterpenoid and oleanolic acid contents in Tibetan medicine Indian Swertia. Chin. J. Ethnomed. Ethnophamacy 2010, 1, 21. [Google Scholar]
- Antolovich, M.; Prenzler, P.; Robards, K.; Ryan, D. Sample preparation in the determination of phenolic compounds in fruits. Analyst 2000, 125, 989–1009. [Google Scholar] [CrossRef]
- Christel, Q.D. Phenolic compounds and antioxidant activities of buckwheat (Fagopyrum esculentum Moench) hulls and flour. J. Ethnopharmacol. 2000, 72, 35–42. [Google Scholar]
- Xu, B.J.; Chang, S.K.C. A comparative study on phenolic profiles and antioxidant activities of legumes as affected by extraction solvents. J. Food Sci. 2007, 72, 159–166. [Google Scholar] [CrossRef] [PubMed]
- Hsu, J.Y.; Chen, M.H.; Lai, Y.S.; Chen, S.D. Antioxidant profile and biosafety of white truffle mycelial products obtained by solid-state fermentation. Molecules 2021, 27, 109. [Google Scholar] [CrossRef] [PubMed]

| Treatment | RF Pasteurization and RF Drying | 121 °C Autoclave and 45 °C Hot-Air Drying |
|---|---|---|
| Mycelium (%) | 5.03 ± 0.12 | 4.94 ± 0.05 |
| Crude polysaccharides (%) | 9.83 ± 0.24 | 9.35 ± 0.30 |
| Crude triterpenoids (%) | 4.43 ± 0.02 | 4.32 ± 0.01 |
| Total polyphenols (mg gallic acid equivalent/g DW) | 3.54 ± 0.21 | 3.55 ± 0.18 |
| Flavonoids (mg quercetin equivalent/g DW) | 0.38 ± 0.03 | 0.33 ± 0.02 |
| Scavenging DPPH free radicals (%) | 93.15 ± 2.46 | 92.11 ± 0.06 |
| Chelating ferrous ion capacity (%) | 91.35 ± 0.33 | 90.98 ± 0.29 |
| Reducing power | 0.71 ± 0.02 | 0.69 ± 0.03 |
| Sample | L* | a* | b* | Whiteness (%) |
|---|---|---|---|---|
| RF pasteurization and RF drying | 53.30 ± 0.31 a | 9.64 ± 0.03 a | 27.70 ± 0.18 a | 44.86 ± 0.21 a |
| 121 °C autoclave and hot-air drying | 41.74 ± 0.03 b | 9.68 ± 0.06 a | 22.65 ± 0.15 b | 36.75 ± 0.07 b |
Publisher’s Note: MDPI stays neutral with regard to jurisdictional claims in published maps and institutional affiliations. |
© 2022 by the authors. Licensee MDPI, Basel, Switzerland. This article is an open access article distributed under the terms and conditions of the Creative Commons Attribution (CC BY) license (https://creativecommons.org/licenses/by/4.0/).
Share and Cite
Yen, Y.-F.; Chen, S.-D. Influence of Radio Frequency Heating on the Pasteurization and Drying of Solid-State Fermented Wolfiporia cocos Products. Foods 2022, 11, 1766. https://doi.org/10.3390/foods11121766
Yen Y-F, Chen S-D. Influence of Radio Frequency Heating on the Pasteurization and Drying of Solid-State Fermented Wolfiporia cocos Products. Foods. 2022; 11(12):1766. https://doi.org/10.3390/foods11121766
Chicago/Turabian StyleYen, Yu-Fen, and Su-Der Chen. 2022. "Influence of Radio Frequency Heating on the Pasteurization and Drying of Solid-State Fermented Wolfiporia cocos Products" Foods 11, no. 12: 1766. https://doi.org/10.3390/foods11121766
APA StyleYen, Y.-F., & Chen, S.-D. (2022). Influence of Radio Frequency Heating on the Pasteurization and Drying of Solid-State Fermented Wolfiporia cocos Products. Foods, 11(12), 1766. https://doi.org/10.3390/foods11121766

